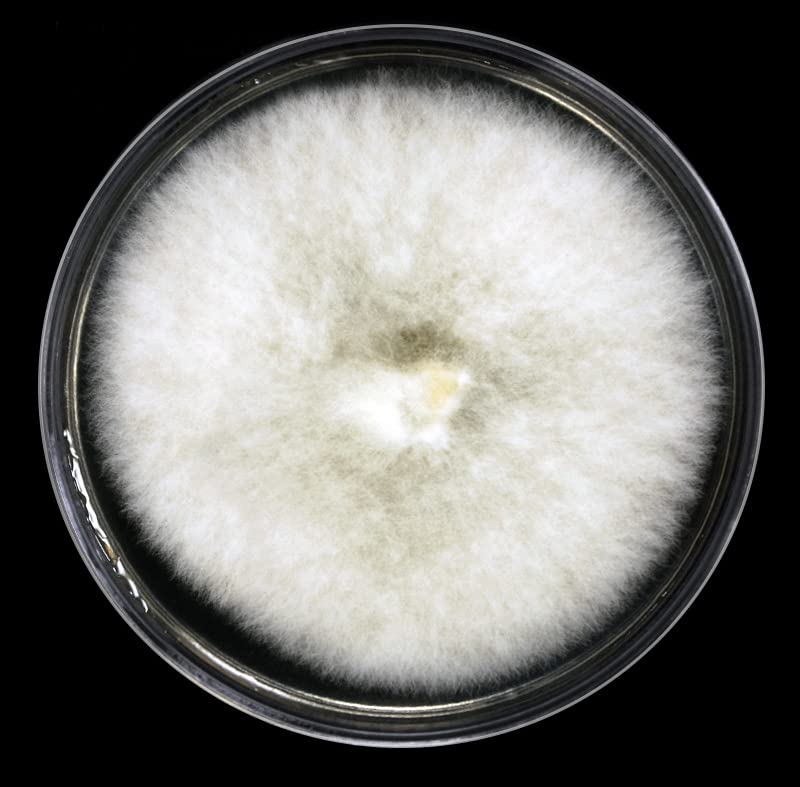
Thumbnail 4

🌱 Elevate Your Wellness Game with MycoMagic!
MycoMagic's Reishi Mushroom Tincture is a high-strength, triple-extracted liquid herbal supplement designed to support immune health, reduce stress, and enhance overall well-being. Grown and manufactured in the UK, this 50ml dropper bottle offers a convenient and pure way to incorporate the benefits of Reishi mushrooms into your daily routine.
| Product Name | Liquid herbal (mushroom) extract |
| Additives | Mushrooms |
| Volume | 50 Millilitres |
| Units | 50.0 millilitre |
| Country of origin of primary ingredient(s) | United Kingdom |
| Brand | MycoMagic |
| Format | Drop |
| Age Range Description | Adult |
Trustpilot
1 week ago
1 month ago